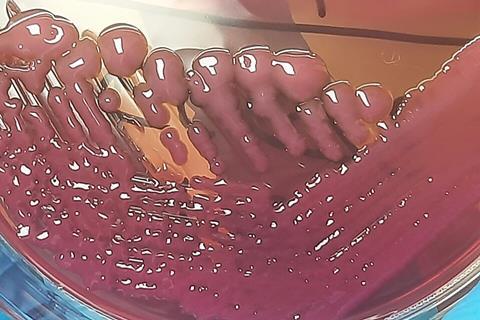
Acinetobacter_baumannii_Complex_on_MacConkey_Agar

Acinetobacter baumannii is a critical-priority, multidrug-resistant pathogen that poses a severe threat in hospitals worldwide. A key structure of these bacteria is the protective layer of complex sugars on its surface, known as capsular polysaccharides (CPS) and lipopolysaccharides (LPS). These structures are essential for the bacterium’s virulence, helping it evade the immune system and resist antibiotics.
In a new review published in Glycoscience & Therapy, a team of researchers in China provided a comprehensive analysis of these molecules. A central finding is the remarkable chemical diversity of these sugars, with over 200 distinct types identified. Many feature rare, non-classical sugars such as pseudaminic acid (Pse), legionaminic acid (Leg), and quinovosamine (Qui), which are promising targets for new therapies.
The authors catalogued the structures of these polysaccharides from various strains, linking their chemical makeup to the genetic loci responsible for their biosynthesis. This detailed structural knowledge is vital because these sugars are ideal candidates for glycoconjugate vaccines. By chemically attaching these bacterial polysaccharides to a carrier protein, scientists can create a vaccine that triggers a strong, protective immune response.

The review highlights that vaccines targeting sugars like Pse have already shown great promise, eliciting protective antibodies and conferring effective immunity in animal models. Nonetheless, a major challenge that remains is the sheer diversity of CPS types; a single-serotype vaccine is insufficient. The authors suggest that a multivalent vaccine, targeting the most prevalent serotypes, is a promising strategy.
No comments yet